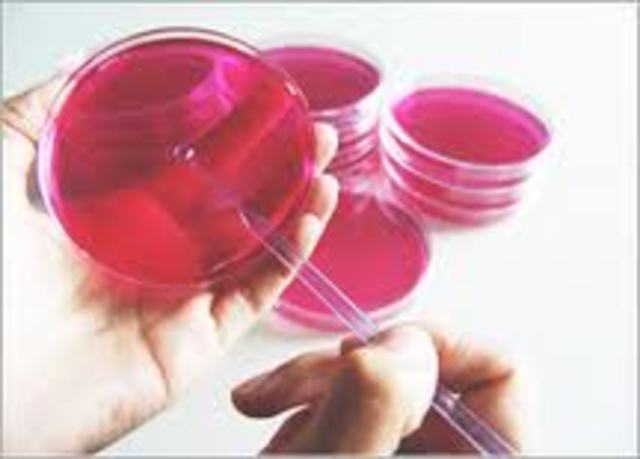
bacterias en medios solidos
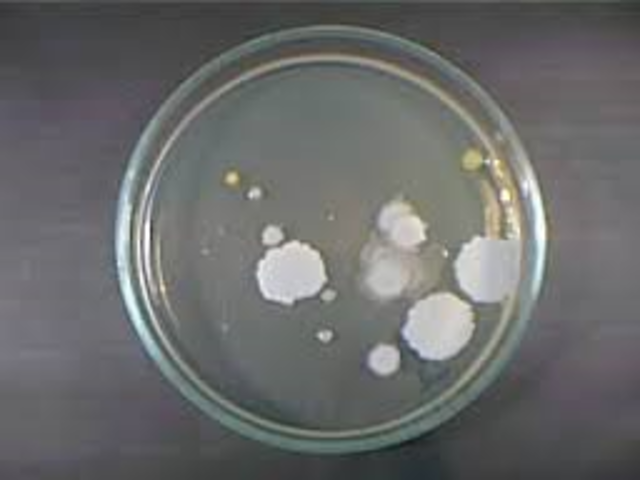
agar-agar

-
Leeuwanhoeck supuso la existencia de microorganismso
-
Francisco Redi. Acaba con la idea de la generación espontánea (Experimento de Redi)
-
Utiliza unos botes de cristal con trozos de carne, dichos botes los tapa con unas gasas que permiten el paso del aire pero de nada más, entonces no se generan "animáculos" en estos trozos de carne
-
Spallauzani. El calentamiento puede evitar la aparición de los animáculos
-
Primeros científicos observaron en primer lugar el virus de la viruela (Edward Jenner)
-
inoculó a un niño fluido procedente de las pústulas vacunales de Sarah Nelmes; semanas después el niño fue inyectado con pus de una pústula de un enfermo de viruela, comprobando que no quedaba afectado por la enfermedad
-
Agostino Bassi demostró que cierta enfermedad del gusano de seda (mal di segno), que había hecho su aparición en Lombardía, se debía a un hongo
-
Erenberg fue el primero en diseñar el primer criterio de clasificación de bacterias, dependiendo de la forma, las bacterias podían ser catalogadas como bastones, espiroquetas (espiral) ó cocos (esféricos)
-
Morton, la técnica es desinfectar primero los utensilios que entrarán en contacto con la herida
-
Rayer. Observó que en la sangre de animales enfermos, había organismos que podían ser causantes de la enfermedad
-
Primera prueba de la teoría germinal de la enfermedad con anthracis descubrimiento (Robert Koch)
-
Pasteur demostró que los agentes de la fermentación láctica eran microorganismos
-
Fue el primero que desarrolló o que aisló un microorganismo en cultivo puro.
-
Crecimiento de bacterias en medios sólidos (Robert Koch)
-
Pasteur cuando ante un gentío expectante se pudo comprobar la muerte del grupo control de ovejas y vacas no inoculadas, frente a la supervivencia de los animales vacunados
-
Hesse descubrio el agar-agar
-
Primera vacunación contra rabia (Louis Pasteur)
-
Berthelot los microorganismos del suelo podían incorporar nitrógeno molecular directamente del aire
-
Inventó la caja Petri (RJ Petri)
-
Loeffler logra visualizar flagelos bacterianos por medio de su técnica de impregnación argéntica
-
Buchner obtuvo, a partir de levaduras, una preparación enzimática (zimasa) que era capaz de realizar la misma transformación de “fermentación” que las células vivas
-
tras analizar la teoría de la mutación de De Vries, había predicho que los microoganismos podrían convertirse en objetos de investigación más adecuados que los sistemas animales o vegetales
-
Maire demostró la existencia de meiosis en la formación de ascosporas
-
F.W. Twort, descubrio los virus vacterianos
-
d'Hérelle fue éste quien acuñó el término bacteriófago, y supuso correctamente que el fenómeno de lisis por estos agentes debía de estar ampliamente difundido entre las bacterias
-
cuajó un Código Internacional de Nomenclatura Bacteriológica, aunque ya se venía aplicando desde hacía tiempo el procedimiento tipológico para los microorganismos, con criterios similares a los de la Zoología y la Botánica.
-
T.O. Diener Los viroides son un grupo de nuevas entidades infectivas, subvirásicas,
-
Los priones son entidades infectivas de un tipo totalmente nuevo y original, descubiertas por Stanley Prusiner
-
Prusiner puso de manifiesto que determinadas enfermedades de mamíferos se deben a partículas proteicas aparentemente desprovistas de material genético, a las que bautizó como priones.
-
se descubrió que el agente de la hepatitis delta humana posee un genomio de ARN de tipo viroide
Looking for a timeline maker?
Create timelines for projects, roadmaps, history, lessons, legal cases, and stories with Timetoast. Timetoast is a timeline maker for work, school, research, and stories.